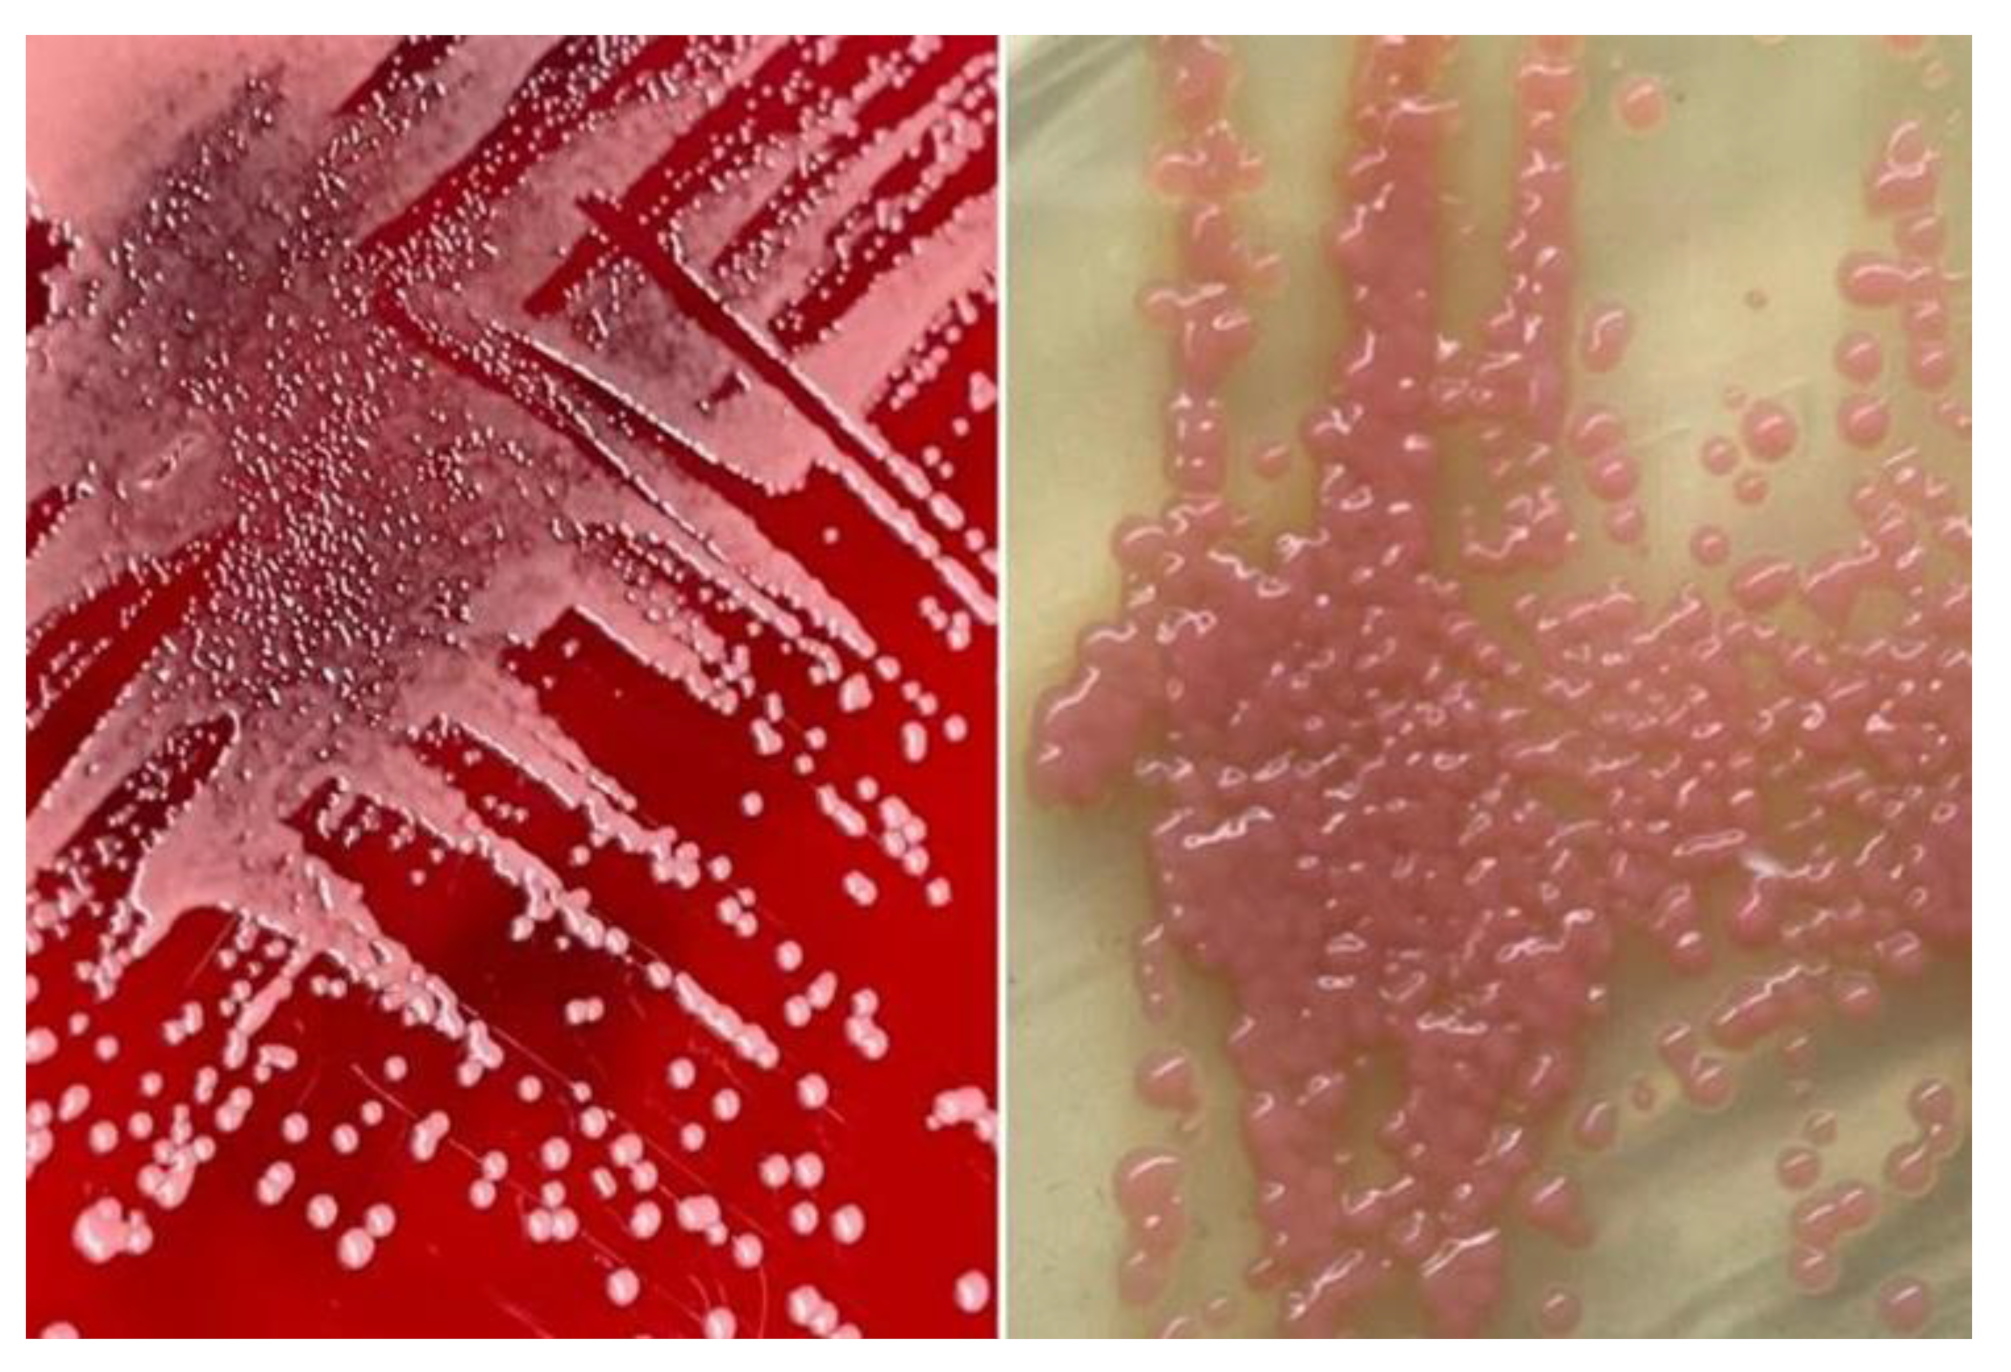

2. Detailed Case Description
We present a case involving a 31-year-old male who was admitted following a high-velocity road traffic accident. Upon assessment in the emergency department, he was intubated due to respiratory compromise identified during the primary survey. His injuries included multiple segmental rib fractures with a right-sided hemopneumothorax, a right-sided Schatzker’s type IV tibial plateau fracture, a grade IV liver injury with right hepatic vein thrombosis, and hemoperitoneum.
Subsequently, he developed abdominal compartment syndrome, manifesting signs of hemodynamic compromise. An urgent contrast-enhanced computed tomography (CECT) of the abdomen revealed gross hemoperitoneum, leading to an urgent laparotomy. During the surgery, bleeding from segment VI of the liver was identified and successfully managed by the hepatobiliary surgeon, with an estimated blood loss of 2.2 liters and was nursed in the intensive care unit (ICU) post-operatively.
In the ICU, the patient developed intra-abdominal sepsis and ventilator associated pneumonia. He was treated empirically with fluconazole for the intra-abdominal sepsis and piperacillin-tazobactam for the ventilator associated pneumonia, however his condition did not improve. Repeated imaging of the abdomen showed presence of biloma (
Figure 1). A percutaneous subdiaphragmatic drain was inserted under computed tomography (CT) guidance by the interventional radiology team. Unfortunately, only a small amount of biloma was drained (less than 5 ml) and the percutaneous drain system got dislodged from its original placement. In view of ineffective percutaneous drain to drain the biloma, the hepatobiliary team decided to perform a hemi-hepatectomy for the removal of the biloma.
Despite removal of biloma, patients’ condition did not improve in the ICU. Inotropes were unable to wean-off and septic parameters including procalcitonin were still high. Blood cultures for bacterial and fungal taken prior to operation were traced, revealing the growth of
Rhodotorula muciloginosa (
Figure 2 and
Figure 3).
After a multidisciplinary discussion involving infectious diseases physicians and clinical microbiologists, it was decided to initiate a course of intravenous meropenem and amphotericin B, given the prolonged ICU admission, multiple indwelling catheters and its minimum inhibitory concentration (MIC) values as shown in
Table 1. Following the new antimicrobial regimen, the patient’s clinical condition significantly improved, as evident by improvement of ventilator settings and parameters, reduction in white cell count, c-reactive protein and procalcitonin.
After a 1-week course of intravenous meropenem and amphotericin B, the patient was successfully weaned off mechanical ventilation and was discharged from ICU care. Intravenous meropenem and amphotericin B were continued in the general surgical ward and were completed for a total duration of 6-weeks from the diagnosis of Rhodotorula mucilaginosa fungaemia as suggested by the infectious disease physician.
3. Discussion
Bile is a lipid-rich sterile solution produced in the liver. However, bacterial colonisation of bile can occur due to trauma or biliary diseases leading to biloma. Biloma is a rare abnormal bilious collection either occur intrahepatic or extrahepatic region. Limited epidemiological data exists concerning the occurrence of biloma formation. The majority of bilomas arise as a consequence of iatrogenic disturbances in the biliary tree. Post-traumatic biloma can take 1 to 2 days to appear [
6]. The clinical presentation of biloma varies as it may present as diffused or localized abdominal pain, jaundice, fever and peritonitis [
7]. They have the propensity to become infected due to microbial ascent, bacteremia, or catheter colonization. Biloma can be infected and may lead to serious and life-threatening complications such as peritonitis, biliopleural fistula and hemobilia [
7]. Infected bilomas are characterized by a collection of pus and bile in the biliary tree, leading to symptoms such as fever, abdominal pain, and jaundice. Approximately 16% of cases are associated with bacteremia at the time of biloma diagnosis [
8]. Fungal infections associated with bilomas are uncommon, with liver transplantation accounting for the majority, presenting an incidence of up to 26% [
9]. However, in this unique case, the patient, an immunocompetent host, developed fungemia associated with a biloma, marking the novelty of this presentation. The deviation from the typical association with liver transplantation underscores the exceptional nature of this particular clinical scenario.
Imaging remains the gold standard for diagnosing bilomas [
10]. Ultrasound (US) is often the initial imaging modality used. US serves a modality capable of detecting the content within the biloma. It may show a variety of findings ranging from well-defined collections in the liver parenchyma to extensive fluid collections across the abdomen. Notably, findings shows heavily loculated bilomas are often linked to infection [
11]. CT imaging can help identify the overall structure of the biloma, delineating clear margins that can be either encapsulated or non-encapsulated [
12]. However, a well-defined capsule is not always present in CT imaging [
12]. On CT imaging, bilomas typically appear as well-defined hypoechoic fluid collections within the abdomen. These collections can vary in size and shape, ranging from small localized areas to larger, more extensive masses. While some bilomas may present with irregular borders [
13]. While CT imaging offers a more intricate view of bilomas, it lacks the capability to conclusively distinguish among various potential diagnoses, including seroma, abscess, lymphocele, liver cyst, hematoma, and pseudocyst [
14]. Consequently, additional imaging modalities such as magnetic resonance (MR) imaging or hepatobiliary cholescintigraphy may be necessary to help validate the diagnosis. Direct sampling of the biloma together with these imaging techniques will also help with the diagnosis [
12]. In T1-weighted images, bilomas will display low signal intensity, whereas in T2-weighted images, high signal intensity is observed [
15]. MR contrast rarely permeates into the biloma and rim-enhancement is sometimes present due to reactive inflammation. Enhancing septations are often observed in superimposed infection [
15]. Hepatobiliary cholescintigraphy serves as a highly efficient non-invasive imaging technique for diagnosing and strategizing treatment for bilomas [
16]. Utilizing a radiotracer known as Tc-99m iminodiacetic acid, it is commonly referred to as hepatobiliary iminodiacetic acid (HIDA) imaging [
12]. HIDA imaging exhibits a high level of sensitivity in detecting bile leaks [
16]. Nonetheless, it lacks the ability to offer detailed imaging of the surrounding anatomical structures. Single positron emission computed tomography (SPECT) can furnish more intricate imaging of potential leak locations, proving particularly valuable in planning percutaneous image-guided drains [
12]. Endoscopic retrograde cholangiopancreatography (ERCP) and Percutaneous transhepatic cholangiogram (PTC) can be considered not only for diagnostic tests but also may offer some degree of intervention either percutaneously or endoscopically [
16]. Other minimally invasive investigations available are CT-guided sampling technique and US-guided sampling technique. However, these techniques require laboratory assistance to analyse the sample collected [
12]. In our case, CT imaging was sufficient to give us the information we need.
The management of bilomas involves a combination of drainage of the fluid collection and antibiotics. Drainage methods, such as percutaneous, endoscopic, or surgical procedures, depend on the location and size of the collection [
10]. Antibiotic therapy should be initiated empirically based on likely pathogens and the patient’s clinical condition, with the choice guided by culture and sensitivity reports. In our case,
Rhodotorula mucilaginosa was isolated from the blood culture, and we posit that its source may have originated either from the biloma, possibly due to environment contamination during the traumatic event, or through opportunistic infection from commensal sites. The initial CT imaging (
Figure 1) revealed a rim-enhancing lesion surrounding the biloma, suggesting a potential infective biloma. However, we did not perform a biopsy and or staining hepatic tissue during the hemi-hepatectomy to definitely confirm that
Rhodotorula mucilaginosa originated from the biloma itself. This limitation underscores a key aspect of our study, highlighting the need for further investigations to establish a direct link between the presence of
Rhodotorula mucilaginosa and the biloma.
Rhodotorula, a yeast often mistaken for Candida species due to its similar morphology, is a low-virulence organism widely distributed in the environment [
3]. Distinguishing between Candida and Rhodotorula sp. based on gram stain can pose considerable challenges, as both exhibit oval budding yeast with rudimentary pseudohyphae [
17]. Utilising the positive urease test as a quick pointer to differentiate between the
Rhodotorula sp. and
Candida sp. can be advocated but it’s important to acknowledge the limitations of this approach, including the test’s positive yield with certain Candida sp. [
18]. Though previously considered non-pathogenic, Rhodotorula sp has emerged as an opportunistic etiologic agent, particularly in cases of fungemia associated with catheters, endocarditis, peritonitis, meningitis, and endophthalmitis [
10]. In a recent review, Rhodotorula fungemia accounted for 48.6% of all Rhodotorula-related infections, with
Rhodotorula mucilaginosa identified as the predominant causative species [
3]. Rhodotorula fungemia has been associated with a crude mortality rate of up to 20%, especially in patients with indwelling vascular catheters, granulocytopenia, impaired anatomic barriers, cellular immune dysfunction, and parenteral nutrition [
19]. Isolation of
Rhodotorula sp. from sterile sites such as blood, peritoneal fluid, or cerebrospinal fluid suggests infection, unlike non-sterile sites like skin, sputum, or stool, as demonstrated in our case report [
20]. Despite lacking apparent immunosuppression, our patient possessed multiple risk factors predisposing him to invasive fungal infections, including ventilator-associated pneumonia, broad-spectrum antimicrobial therapy, admission to the critical care unit with CVC access, and urinary catheterization, all significant contributors to invasive fungal infection. Persistent sepsis despite biloma removal and administration of potent broad-spectrum antibiotics raised suspicion of fungal infection. Therefore, clinical judgment dictated coverage with Amphotericin B and meropenem to address the fungal infection.
Managing bilomas in combination with
Rhodotorula mucilaginosa fungemia poses a challenge. This necessitates a multidisciplinary approach involving infectious disease physicians, interventional radiologists, and surgeons. In the past, surgery was the only option in treating biloma but with the advancement of medical technology more options are currently available [
7]. The optimal approach to treating bilomas hinges on several factors, including the patient’s overall health, the size and location of the biloma, the presence of biliary leakage, and the occurrence of sepsis [
21]. Several treatment options are available including percutaneous or endoscopic drainage, surgical drainage, or close monitoring [
12]. Small biloma does not necessitate any treatment and close observation is suffice [
7]. Percutaneous drainage, the most common method, is associated with lower morbidity and mortality compared to surgical drainage [
22]. In our case, the patient initially underwent CT-guided drainage of the biloma. Unfortunately, our initial attempt at percutaneous drainage proved unsuccessful, likely due to the presence of multiple septated collections within the biloma. While additional drainage procedures could be considered, introducing more drains poses an increased risk of infection for the patient. Endoscopic drainage was not suitable for our case as it requires large collections and those located in the left lobe of the liver. Eventually, due to persistent sepsis, our patient necessitated a hemi-hepatectomy for source control, underscoring the role of surgical intervention in cases where percutaneous drainage fails or bile leaks persist.
Several in vitro studies showed
Rhodotorula sp. are resistant to fluconazole and echinocandin, however more susceptible to other azoles such as voriconazole and itrconazole [
23,
24,
25]. Given the high resistance of fluconazole, alternative antifungal agents such as voriconazole, caspofungin, or amphotericin B should be considered. In our case, concentration gradient tests were conducted, revealing a low minimum inhibitory concentration (MIC) for amphotericin B, indicating susceptibility. However, the other antifungals, azoles (fluconazole, itraconazole, posaconazole, voriconazole), and echinocandins (anidulafungin, caspofungin) showed high MICs, indicating poor response to treatment (
Table 1). Another case of
Rhotodorula mucilaginosa fungaemia reported in literature showed that the MIC was comparable with our finding with amphotericin B and fluconazole was 0.25 μg/mL and 128 μg/mL respectively [
5]. Clinically, this was evident when the patient’s condition did not improve despite adequate dosing and duration of fluconazole during the initial treatment.
In addition to the patient’s clinical response and infection resolution, several other factors contribute to determining the duration of antifungal therapy. These factors include the severity of the infection, the presence of underlying medical conditions, such as diabetes or immunosuppression, and the risk of recurrence. Close monitoring of the patient’s symptoms, laboratory results, and imaging findings is essential in assessing the effectiveness of the antifungal treatment and guiding the decision regarding treatment duration In our case, the decision to administer a total of six weeks of targeted antifungal therapy from the point of diagnosis was based on a thorough evaluation of these factors. Regular follow-up examinations and imaging studies were conducted to track the progress of the treatment and ensure the resolution of the infection. Regarding the role of prophylactic antifungal therapy in patients with infected biloma, while some studies suggest its potential benefits in reducing fungal infections, especially in immunocompromised individuals, controversy exists regarding its routine use [
26,
27,
28]. Prophylactic antifungal therapy may carry risks, such as the development of antifungal resistance and adverse drug reactions, which need to be weighed against its potential benefits [
29]. Therefore, its use should be carefully considered on a case-by-case basis, with preference given to high-risk patients, such as those undergoing extensive surgical procedures or with significant immunosuppression [
28]. Close collaboration between infectious disease specialists, hepatobiliary surgeons, and other relevant healthcare providers is crucial in making informed decisions regarding prophylactic antifungal therapy in this patient population.
The prognosis of infected biloma combined with
Rhodotorula mucilaginosa fungemia is generally favourable if diagnosed early and managed appropriately. However, delayed diagnosis or inappropriate management can lead to severe morbidity and mortality. The mortality rate in cases of
Rhodotorula mucilaginosa fungemia ranges from 30% to 50% [
20]. Factors associated with poor outcomes include delays in initiating appropriate antifungal therapy, sepsis, and underlying comorbidities such as liver disease [
29]. In addition to the factors mentioned, the presence
of Rhodotorula mucilaginosa fungemia may also increase the risk of disseminated infection, potentially affecting multiple organ systems and complicating treatment. Therefore, early recognition of systemic involvement and prompt initiation of systemic antifungal therapy are crucial to prevent disease progression and improve prognosis [
12]. Furthermore, the immune status of the patient plays a significant role in determining outcomes, with immunocompromised individuals facing a higher risk of severe complications and mortality. As such, efforts to optimize immune function through supportive measures or targeted interventions may contribute to better treatment responses and enhanced survival rates. Overall, a comprehensive understanding of the multifactorial nature of infected biloma with
Rhodotorula mucilaginosa fungemia is essential for devising effective management strategies and improving patient outcomes.